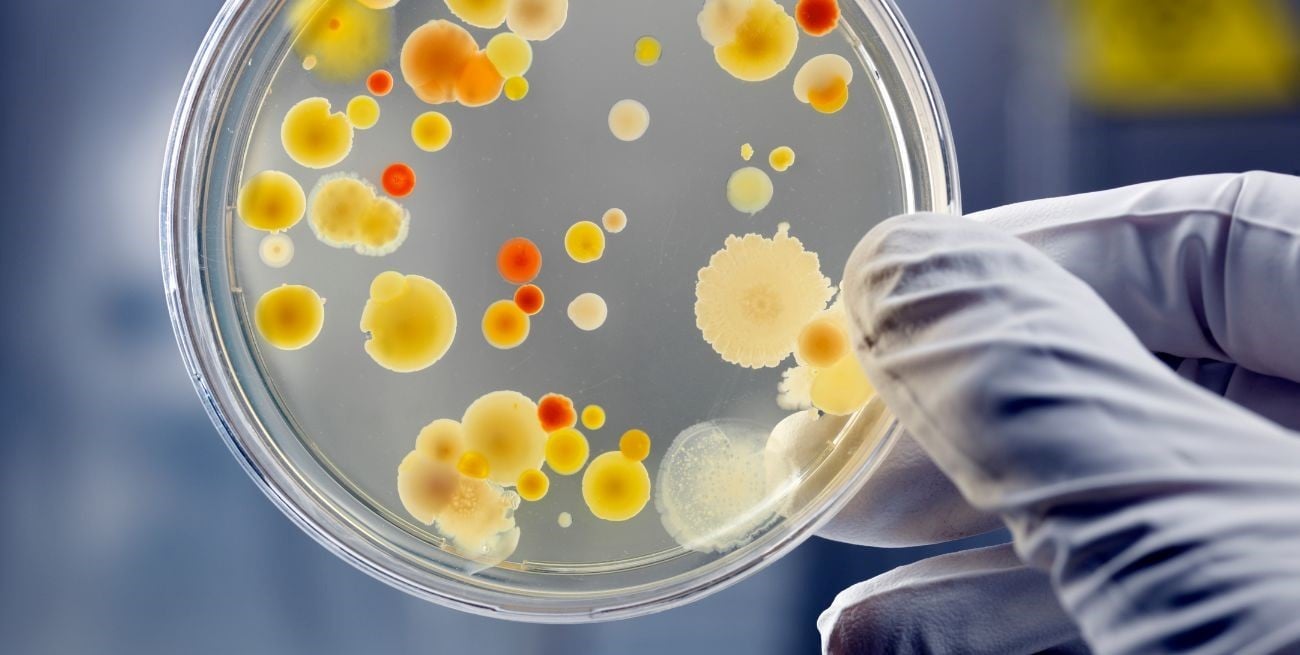

Cuando pensamos en los objetos más sucios de nuestra casa, es común que el inodoro se lleve toda la atención.
¿Cuál es el objeto en tu casa con más bacterias que cualquier superficie del baño?


Sin embargo, la realidad es que hay un objeto en tu hogar que puede tener incluso más bacterias que el inodoro y que podría estar afectando tu salud: la esponja de cocina.
Criadero de bacterias
Las esponjas de cocina son esenciales en la limpieza diaria, pero también son el hogar perfecto para una multitud de bacterias. Esto ocurre porque las esponjas están en contacto constante con restos de comida y humedad, dos factores que favorecen el crecimiento bacteriano.
De hecho, estudios han demostrado que una esponja de cocina puede albergar hasta 10 millones de bacterias por centímetro cuadrado, una cifra mucho mayor que la que se encuentra en la superficie de un inodoro.

¿Por qué es tan problemática?
- Humedad y restos de comida: las esponjas permanecen húmedas la mayor parte del tiempo, lo que crea un entorno ideal para las bacterias. Los restos de comida que quedan atrapados en la esponja también sirven de alimento para estos microorganismos.
- Contacto directo con alimentos: cada vez que usas la esponja para limpiar platos, utensilios o superficies de cocina, estás en contacto directo con las bacterias que alberga. Esto puede transferir bacterias a los alimentos que consumes, aumentando el riesgo de enfermedades gastrointestinales.
- Transferencia de bacterias: las esponjas a menudo se usan en varias superficies, desde la cocina hasta el fregadero y las superficies de los electrodomésticos, lo que puede facilitar la transferencia de bacterias de un lugar a otro.

¿Cómo puedes reducir el riesgo?
- Limpieza regular: lava la esponja a fondo con agua caliente y un detergente antibacteriano después de cada uso. También puedes ponerla en el microondas durante unos minutos (sin restos de metal) para matar las bacterias.
- Sustitución frecuente: cambia la esponja cada 1-2 semanas. Aunque las esponjas se pueden limpiar, con el tiempo se desgastan y acumulan demasiadas bacterias.
- Uso alternativo: considera el uso de alternativas a las esponjas tradicionales, como estropajos de acero inoxidable o cepillos de cocina que se pueden lavar y secar más fácilmente.
- Secado adecuado: asegúrate de que la esponja se seque completamente entre usos. La humedad constante es el principal factor en el crecimiento bacteriano.
La esponja de cocina, aunque esencial para mantener la limpieza en tu hogar, es uno de los objetos más insidiosos en cuanto a acumulación de bacterias.
Al implementar prácticas de limpieza y sustitución regulares, puedes reducir significativamente el riesgo de que estas bacterias afecten tu salud. Mantén tu esponja bajo control para protegerte de enfermedades y garantizar un ambiente de cocina más saludable.

Dejanos tu comentario
Los comentarios realizados son de exclusiva responsabilidad de sus autores y las consecuencias derivadas de ellos pueden ser pasibles de las sanciones legales que correspondan. Evitar comentarios ofensivos o que no respondan al tema abordado en la información.